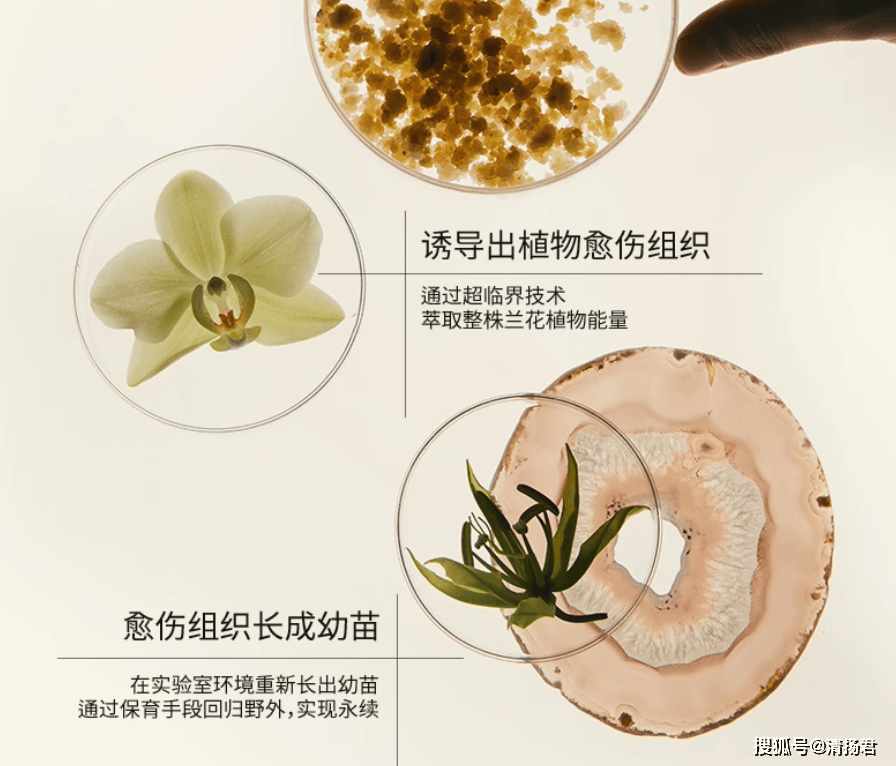
护肤品牌“LAN”陷备案风波:杭州上城区市监局已介入处理(图2)

护肤品牌“LAN”陷备案风波:杭州上城区市监局已介入处理
一边是消费者较真投诉,一边是品牌方信誓旦旦宣称合规,护肤品牌“LAN”的“时光兰花系列”产品,正陷入一场备案与宣传不符的争议漩涡。
据澎湃新闻报道,成都消费者张琦(化名)从李佳琦直播间和天猫“兰旗舰店”购买的9款“蘭时光”系列产品,涉嫌将新原料“白及兰、虾脊兰愈伤组织”,套用《已使用化妆品原料目录》中已有的“兰科植物提取物”进行备案和销售。他认为,这不仅是标注不规范,更可能存在原料安全风险。

值得说明的是,张先生的质疑并非空穴来风。他购买的“蘭时光”兰花臻颜精萃油(时光油3.OPro)、“蘭时光”兰花焕活精萃油(气泡油2.0Pro)、“蘭时光”兰花臻妍精萃油、“蘭时光”兰花悦活精萃油等9款产品,在备案信息和包装上均标注为“兰科植物提取物”,而品牌在天猫产品页面和小红书官方账号中,却明确宣传使用的是通过生物技术培养的“白及兰、虾脊兰植物愈伤组织”。
通过药监局官网查询发现,蘭时光兰花臻颜精萃油的备案编号是“浙G妆网备字2025013197”,备案人为杭州兰匠化妆品有限公司,生产企业分别为广州科丸生物科技有限公司、上海茵派化妆品有限公司、湖州嘉亨实业有限公司、上海嘉亨日用化学品有限公司和蝶柔化妆品(浙江)有限公司。
与此同时,清扬君注意到,“蘭时光兰花臻颜精萃油”备案的实验室试验简述显示,所用原料明确标示为“虾脊兰(CALANTHE DISCOLOR)提取物(兰科植物ORCHID提取物)”,并简述其具有表皮修护作用。该表述与网页宣传中使用的“愈伤组织细胞”并不一致。
公开资料显示,「兰」品牌2020年营收达2亿元人民币。值得一提的是,该品牌在2021年4月之前的六个月内,连续完成了两轮融资,总额也恰好为2亿元。其中,前一轮由天图资本独家投资,后一轮则由源码资本领投,天图资本与内向资本跟投。
张先生的质疑,看似只是名称差异,实则牵出一个关键问题:植物愈伤组织能否等同于植物提取物?
品牌客服的回应是:“双兰精粹”(白及兰、虾脊兰植物愈伤组织)就是“兰科植物提取物”。但也有专家的观点却与此相左。国家药品监督管理局何淼、中国医学科学院药用植物研究所石钺等专家撰写的《化妆品原料现状及应用发展》一文中指出,《已使用化妆品原料目录》中“间接来源于植物的原料”,如莲(NELUMBO NUCIFERA)叶细胞培养物粉、苹果(MALUSDOMESTICA)果实细胞培养物提取物等,不能归属于植物原料,“因为其与植物原料的形态、化学组成及化学结构等差异明显。”
不过也有业内人士指出,争议的核心在于法规更新滞后于技术发展。其逻辑在于,现行法规将直接提取、发酵和愈伤组织培养等不同工艺获得的同类成分视为同一原料。这种归类方式一方面避免了因过度细分而导致的监管复杂化,另一方面也有助于控制产品成本,防止因分类过细而推高企业和消费者的负担。
值得说明的是,2024年3月,杭州拾光欣雅生物技术有限公司曾申请了“虾脊兰植物愈伤组织提取物在制备护肤产品/化妆品中的应用”发明专利,但在2025年10月转让给了杭州兰匠化妆品有限公司。该说明书称,这是一种“新原料”,并总结称,“虾脊兰愈伤组织提取物“相比于‘虾脊兰植株提取物’,能够更好地促进细胞中胶原蛋白、纤维蛋白基因的表达,即虾脊兰愈伤组织延缓肌肤衰老的效果优于虾脊兰植株。

清扬君注意到,杭州拾光欣雅生物技术有限公司还备案了一种无花果愈伤组织提取物及其制备方法和应用、一种牡丹愈伤组织提取物及其制备方法与应用、一种梅花愈伤组织提取物的制备方法及其应用、昙花愈伤组织提取物在制备化妆品中的应用等专利。
此外,杭州兰匠化妆品有限公司备案了华白及(Bletilla sinensis)愈伤组织提取物新原料(国妆原备字20250083),杭州拾光欣雅生物技术有限公司备案了昙花(Epiphyllum oxypetalum)愈伤组织提取物的新原料(国妆原备字20250033)。
一边在专利中区分“愈伤组织”与“植株”,一边在备案中坚称合规却宣传“愈伤组织”,难免让人生疑。
面对质疑,LAN品牌母公司杭州兰匠化妆品有限公司回应称,其“时光兰花系列”产品完全合规。所用“兰科植物提取物”具体成分为《已使用化妆品原料目录》收录的“白及提取物”与“虾脊兰提取物”,所有原料均已在药监局系统完成报送,备案时按原料商正式文件使用类别名称标注,符合法规要求。此外,原料添加量在法定安全范围内,并经第三方检测机构多项毒理测试(包括急性经皮毒性、眼刺激、皮肤刺激等),结果均显示“无毒、无刺激”。品牌强调,安全合规是经营的根本底线,始终严格遵循国家标准。
然而,声明并未直接回应核心问题:为何宣传中的“愈伤组织”在备案中消失不见?品牌方声称“依据原料企业提供的正式报送文件标注”,等于将皮球踢给原料商,而原料商“浙江未名拾光生物技术有限公司”(杭州拾光欣雅生物技术有限公司母公司)在“声明”中称,该公司在原料的上市前备案阶段,已依照国家《化妆品注册备案管理办法》的要求,将包括核心制备工艺、质量标准及安全信息在内的全部资料,通过国家药监局指定的备案平台进行了完整、如实地报送,不存在任何违法违规问题。但也未能进一步说明植物愈伤组织是否等同于植物提取物。
事实上,无论杭州兰匠化妆品有限公司还是江未名拾光生物技术有限公司,都备案了“愈伤组织”的新原料,更应明确区分新原料与已使用原料,而非模糊处理。
目前我国对化妆品新原料实行严格管理,新原料需经过3年安全监测期方可纳入已使用目录。品牌方若确实使用了新原料,就应按规定进行新原料备案,而非套用旧名称。
目前,国家药监局已将张先生的投诉转交浙江、广东、山东等地监管部门核查。杭州市上城区市场监督管理局正介入处理。
此事看似是专业术语之争,实则是化妆品行业创新与监管的典型博弈。品牌追求营销亮点无可厚非,但必须在法规框架内行事。如果打着“科技成分”的擦边球,却回避新原料的严格监管,不仅对消费者不公,更可能损害行业信誉。
监管部门的态度将至关重要。我们期待一个明确的结论:这究竟是合规的类别标注,还是刻意规避新原料监管的投机行为?
消费者有权知道,抹在脸上的“科技成分”,究竟是不是真正的“新原料”。而品牌方若想以“创新”为卖点,就更应以透明、规范的方式接受监管。












